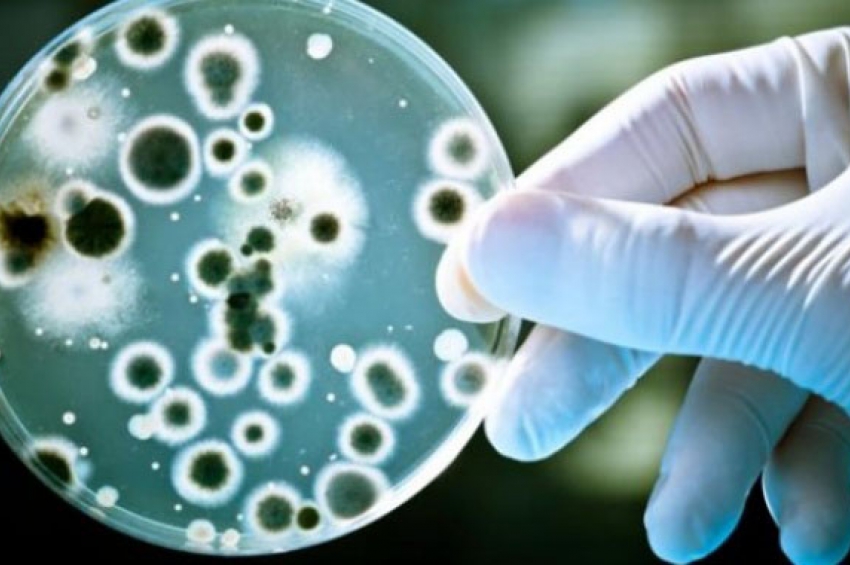

Световни новини
Бактериалната инфекция взе жертви в Шотландия
Бактериалната инфекция взе жертви в Шотландия
Две деца под 10 години починаха в Шотландия от бактериалната инфекция, причинявана от стрептококи от Група А, с което общият брой на жертвите за цялото Обединено кралство достигна 26.
От общественото здравеопазване на Шотландия потвърдиха, че двете деца са под 10 години и са починали между октомври и декември. Общо жертвите в Шотландия са 7. Общо 26 деца са починали от заразата във Великобритания, но за първи път се съобщава за смъртни случаи в Шотландия, предава БНР.
Шотландският министър на здравеопазването Хамза Юсаф написа в Twitter, че „всеки смъртен случай е трагедия, особено на малки деца, но добрата новина е, че повечето случаи на бактериална инфекция са сравнително леки и могат да се лекуват с антибиотици. Той допълни, че работи ефективно с британските власти за доставка на лекарствата.
Миналата седмица фармацевтите получиха разрешително да предписват свободно антибиотик или алтернативи на пеницилин за лечение на заболяването. Даването на антибиотици във Великобритания за по-масова употреба е голяма рядкост.
От Световната здравна организация информираха, че смъртоносната инфекция е засечена и в други европейски държави като Франция, Ирландия, Нидерландия и Швеция.
Вече се говори за напреднал стадий на разработване на специална ваксина срещу заболяването.
От общественото здравеопазване на Шотландия потвърдиха, че двете деца са под 10 години и са починали между октомври и декември. Общо жертвите в Шотландия са 7. Общо 26 деца са починали от заразата във Великобритания, но за първи път се съобщава за смъртни случаи в Шотландия, предава БНР.
Шотландският министър на здравеопазването Хамза Юсаф написа в Twitter, че „всеки смъртен случай е трагедия, особено на малки деца, но добрата новина е, че повечето случаи на бактериална инфекция са сравнително леки и могат да се лекуват с антибиотици. Той допълни, че работи ефективно с британските власти за доставка на лекарствата.
Миналата седмица фармацевтите получиха разрешително да предписват свободно антибиотик или алтернативи на пеницилин за лечение на заболяването. Даването на антибиотици във Великобритания за по-масова употреба е голяма рядкост.
От Световната здравна организация информираха, че смъртоносната инфекция е засечена и в други европейски държави като Франция, Ирландия, Нидерландия и Швеция.
Вече се говори за напреднал стадий на разработване на специална ваксина срещу заболяването.

.jpg)
Comments
comments powered by Disqus